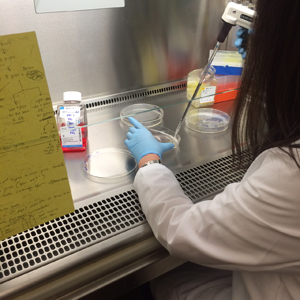
Student working at a tissue culture hood

Why Do We Study Cytomegalovirus?

- Cytomegalovirus is an important human pathogen:
- Cytomegalovirus is a herpesvirus.
- Up to 80% of people are infected by adulthood.
- Primary infections are generally not serious, but the virus establishes a lifelong persistent/latent infection.
- The virus can periodically reactivate with little or no symptoms, and spread to new hosts through bodily fluids.
- Reactivations can cause serious complications in people with comprimised immune systems:
- untreated HIV/AIDS
- transplant recipients who recieve anti-rejection drug
- Intrauterine infections (mother-to-child)
- 1 in 150 children born with CMV infection
- 1 in 5 intrauturine infections result in clinicially observable symptoms such as nerve deafness and developmental delays.
- Information and statistics about cytomegalovirus from Centers for Disease Control (CDC).
- Studying any virus can uncover important molecular biology principles that can have broad implications.
- In the early 20th century, the biochemical nature of the "genetic information" was unclear.
- Viruses that infect bacteria ("bacteriophages") were espectially amendable to the laboratory methods of the time.
- Basic research into the molecular mechanisims of bacteriophage replication by Alfred Hershey and Martha Chase (among others) led to the appreciation that nucleic acids (DNA and RNA) are the carriers of genetic information for viruses, and all life forms on earth.
- Read the original 1952 Hershey/Chase research article.
What are our research questions?
- Viral Tropism: What cell types and tissues can a virus infect?
- An important determinate of viral tropism is the receptor interactions between viral surface proteins, and the surface proteins (receptors) on host cell surfaces, which can be very differnet depending on the cell and tissue type.
- Most viruses infect and replicate in a limited number of cell types and tissues in the body.
- Human cytomegalovirus can be found in many cell types in many tissues.
- Viral tropism correlates with the variety of surface proteins a virus has
- human immunodeficency virus (HIV) has 1 type of surface protein (env). Consequently, HIV infection is mostly limited to cells bearing the CD4 receptor (eg., CD4+ "helper" T-cells).
- The surface proteins of human cytomegalovirus are not fully characterized, but may include more than 20 different types of proteins. Consequently, this virus may have many more options of receptors, and this may help explain the unusually broad tropsim.
- A major focus of our research efforts are to better understant the complexity of the cytomegalovirus surface proteins and how they mediate infection of different cell types.
- The effects of genetic diversity on HCMV biology.
- The scope of HCMV genetic diversity in nature is only recently becoming apprciated.
- How genetic diversity affects the biology of HCMV replication is pooly understood.
- Most studies of HCMV molecular biology have used one of several genetically pure "lab-adapted" strains or isolates.
- We are very interested in how genetic diversity of HCMV influences the surface glycoproteins that mediate entry into different cell types.
What are our research approaches?

- Comparative analysis of genetically distinct HCMV isolates
- Mutagenesis of viral proteins
- Cell culture based analysis of virus replcation
- Protein anlyses
- metabolic radiolabeling
- electrophoretic seperation of protein species
- immunoprecpitation
- immunoblot (western blot)
- Confocal fluorescence microscopy
- Computational modleing of protein structure
- Structural characterization of proteins (e.g. X-Ray crystallography)
- Core facilities of the University of Montana
